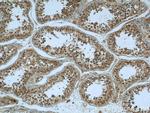
KIF15 Antibody in Immunohistochemistry (Paraffin) (IHC (P))

Search
Proteintech
KIF15 Polyclonal Antibody
{{$productOrderCtrl.translations['antibody.pdp.commerceCard.promotion.promotions']}}
{{$productOrderCtrl.translations['antibody.pdp.commerceCard.promotion.viewpromo']}}
{{$productOrderCtrl.translations['antibody.pdp.commerceCard.promotion.promocode']}}: {{promo.promoCode}} {{promo.promoTitle}} {{promo.promoDescription}}. {{$productOrderCtrl.translations['antibody.pdp.commerceCard.promotion.learnmore']}}
产品信息
55407-1-AP
种属反应
已发表种属
宿主/亚型
分类
类型
抗原
偶联物
形式
浓度
规格
纯化类型
保存液
内含物
保存条件
运输条件
靶标信息
Plus-end directed kinesin-like motor enzyme involved in mitotic spindle assembly. Target protein's mouse homolog associates with microtubulew and appears to play a role in mitosis in fibroblasts and in migration in developing neurons.
仅用于科研。不用于诊断过程。未经明确授权不得转售。
生物信息学
蛋白别名: hKLP2; kinesin 15; kinesin-like 7; Kinesin-like protein 2; Kinesin-like protein 7; Kinesin-like protein KIF15; N-10 kinesin; Serologically defined breast cancer antigen NY-BR-62; unnamed protein product
基因别名: 3110023M17Rik; 3930402I10Rik; b2b1117.1aClo; b2b1117.1Clo; BRDCS2; D330038N01; HKLP2; KIF15; KLP2; KNSL7; NY-BR-62
UniProt ID: (Human) Q9NS87, (Rat) Q7TSP2, (Mouse) Q6P9L6
Entrez Gene ID: (Human) 56992, (Rat) 353302, (Mouse) 209737